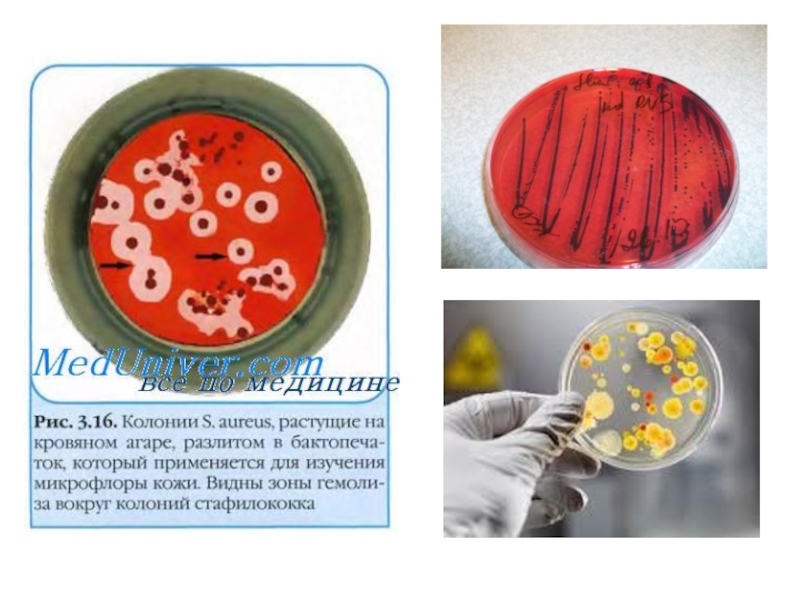

продуктов, обсемененных различными микроорганизмами и содержащих бактериальные токсины; характеризуются внезапным началом, бурным развитием, интоксикацией, гастроэнтеритом и нарушением водно‑солевого обмена.
Пищевые токсикоинфекции нередко носят групповой характер (вспышечная заболеваемость).
- Главная
- Разное
- Дизайн
- Бизнес и предпринимательство
- Аналитика
- Образование
- Развлечения
- Красота и здоровье
- Финансы
- Государство
- Путешествия
- Спорт
- Недвижимость
- Армия
- Графика
- Культурология
- Еда и кулинария
- Лингвистика
- Английский язык
- Астрономия
- Алгебра
- Биология
- География
- Детские презентации
- Информатика
- История
- Литература
- Маркетинг
- Математика
- Медицина
- Менеджмент
- Музыка
- МХК
- Немецкий язык
- ОБЖ
- Обществознание
- Окружающий мир
- Педагогика
- Русский язык
- Технология
- Физика
- Философия
- Химия
- Шаблоны, картинки для презентаций
- Экология
- Экономика
- Юриспруденция
Токсикоинфекции пищевые презентация
Содержание
- 2. Токсикоинфекции пищевые – остро протекающие инфекционные
- 3. По данным Всемирной организации здравоохранения, миллионы взрослых
- 5. Этиология ПТИ вызывает большая группа бактерий;
- 7. Bacillus cereus — грамположительная спорообразующая подвижная палочка,
- 9. Источник инфекции - различные животные и люди.
- 11. Факторы передачи
- 16. Выделяют следующие типы пищевых токсикоинфекции. 1.
- 17. Патогенез Общее свойство для всех
- 18. Инкубационный период. Составляет, как правило, несколько часов,
- 19. Для заболеваний характерно острое начало с тошноты,
- 23. При осмотре больных отмечают бледность кожных
- 25. Стафилококковой инфекции свойственны короткий инкубационный период и
- 26. Диагностика -Пищевые токсикоинфекции Наибольшее значение в
- 27. Лабораторная диагностика пищевых токсикоинфекций Диагноз пищевой
- 30. Лечение. Больные с пищевыми токсикоинфекциями должны направляться
- 33. При тяжелом течении, инфекционно-токсическом шоке, неукротимой рвоте
- 34. При тяжелой рвоте можно применять противорвотные средства,
- 35. Всем больным назначают щадящую диету (№
- 36. Фитотерапия Фитотерапия направлена на восстановление
- 37. Профилактика. Залогом успешной борьбы с ПТИ
- 38. Медсестринский процесс І Этап. Медсестринское обследование.
- 39. Медсестринский процесс
- 40. ІІ етап. Медсестринская диагностика: Тошнота, рвота. Боль в животе. Диарея. Лихорадка. Обезвоживание.
- 41. III этап - Планирование медсестринских вмешательств 1.
- 42. ІV этап. Реализация плана медсестринских вмешательств
- 43. Выполнение врачебных назначений : Перорально: сорбенты, дезинтоксикационные
- 44. V этап. Оценка результатов медсестринских вмешательств
- 45. Каждый
Слайд 2 Токсикоинфекции пищевые – остро протекающие инфекционные заболевания, возникающие после употребления
Слайд 3По данным Всемирной организации здравоохранения, миллионы взрослых людей по всему миру
умирают от бактерий и токсинов, содержащихся в еде. Пищевые токсикоинфекции намного опаснее и чаще приводят к летальному исходу, чем полагали специалисты ранее, сообщает ООН.
В ходе исследования удалось выяснить, что опасные продукты питания виновны в смерти 1,2 миллионов человек ежегодно в Юго-Восточной Азии и Африке. Также показатели смертности в мире от пищевых токсикоинфекций в три раза выше, чем предполагалось ранее, сообщили представители ВОЗ.
В ходе исследования удалось выяснить, что опасные продукты питания виновны в смерти 1,2 миллионов человек ежегодно в Юго-Восточной Азии и Африке. Также показатели смертности в мире от пищевых токсикоинфекций в три раза выше, чем предполагалось ранее, сообщили представители ВОЗ.
Слайд 5Этиология
ПТИ вызывает большая группа бактерий; основные возбудители -
Staphylococcus aureus,
Esherichia coli,
S.
Enteritidis,
Shigeiia
Proteus vulgaris,
Bacillus cereus,
Clostridium perfringens,
Clostridium difficile,
представители родов Klebsiella,
Enterobacter, Citrobacter,
Serratia,
Enterococcus и др.
Возбудители широко распространены в природе, обладают выраженной устойчивостью и способны размножаться в объектах внешней среды.
Все они являются постоянными представителями нормальной микрофлоры кишечника человека и животных.
Shigeiia
Proteus vulgaris,
Bacillus cereus,
Clostridium perfringens,
Clostridium difficile,
представители родов Klebsiella,
Enterobacter, Citrobacter,
Serratia,
Enterococcus и др.
Возбудители широко распространены в природе, обладают выраженной устойчивостью и способны размножаться в объектах внешней среды.
Все они являются постоянными представителями нормальной микрофлоры кишечника человека и животных.
Слайд 7Bacillus cereus — грамположительная спорообразующая подвижная палочка, факультативный анаэроб. Будучи распространенным
почвенным сапрофитом, эта бактерия повсеместно встречается в окружающей среде и нередко высевается из мяса, овощей, яиц и молочных продуктов. Bacillus cereus вызывает два типа кишечных заболеваний: пищевой токсикоз (отравление пищей, содержащей термостабильный токсин; среди симптомов преобладает рвота) и пищевую токсикоинфекцию (инфекция с образованием токсина в ЖКТ; среди симптомов преобладает понос).
Слайд 9Источник инфекции - различные животные и люди.
Наиболее часто это лица,
страдающие гнойными заболеваниями (панарициями, ангинами, фурункулёзом и др.);
среди животных - коровы и овцы, болеющие маститами. Все они выделяют возбудитель (обычно стафилококки), попадающие в пищевые продукты в процессе их обработки, где и происходит размножение и накопление бактерий.
Возбудители других токсикоинфекций (С. perfringens, В. cereus и др.) люди и животные выделяют во внешнюю среду с испражнениями.
Резервуаром ряда возбудителей могут являться почва, вода и другие объекты внешней среды, загрязнённые испражнениями животных и человека.
Естественная восприимчивость людей высокая.
среди животных - коровы и овцы, болеющие маститами. Все они выделяют возбудитель (обычно стафилококки), попадающие в пищевые продукты в процессе их обработки, где и происходит размножение и накопление бактерий.
Возбудители других токсикоинфекций (С. perfringens, В. cereus и др.) люди и животные выделяют во внешнюю среду с испражнениями.
Резервуаром ряда возбудителей могут являться почва, вода и другие объекты внешней среды, загрязнённые испражнениями животных и человека.
Естественная восприимчивость людей высокая.
Слайд 16Выделяют следующие типы пищевых токсикоинфекции.
1. Острые гастроэнтериты, вызываемые экзотоксинами (энтеротоксинами). Известно,
что некоторые микроорганизмы вырабатывают токсины, которые нарушают всасывание в кишечнике и вызывают секрецию электролитов и воды. Особенно бурную секрецию вызывают энтеротоксины холерного вибриона. Аналогичный механизм диареи, хотя и менее выраженный, вероятно, имеет место и при диарее туристов.
2. Острые гастроэнтериты, вызываемые бактериальными эндотоксинами, которые проникают в слизистую оболочку тощей или толстой кишки. Токсины повреждают стенку кишки, вызывают изъязвления, кровотечение, секрецию белка, воды и электролитов в просвет кишки. Такой механизм наблюдается при гастроэнтерите, вызываемом шигеллами, сальмонеллами и эшерихиями коли.
3. Острые гастроэнтериты с малоизвестным патогенезом.
К ним относится диарея туристов.
2. Острые гастроэнтериты, вызываемые бактериальными эндотоксинами, которые проникают в слизистую оболочку тощей или толстой кишки. Токсины повреждают стенку кишки, вызывают изъязвления, кровотечение, секрецию белка, воды и электролитов в просвет кишки. Такой механизм наблюдается при гастроэнтерите, вызываемом шигеллами, сальмонеллами и эшерихиями коли.
3. Острые гастроэнтериты с малоизвестным патогенезом.
К ним относится диарея туристов.
Слайд 17Патогенез
Общее свойство для всех возбудителей пищевых токсикоинфекций - способность вырабатывать различные
типы экзотоксинов (энтеротоксинов) и эндотоксинов (липополисахаридных комплексов). Именно благодаря особенностям действия этих токсинов отмечают определённое своеобразие в клинических проявлениях пищевых токсикоинфекций, обусловленных различными возбудителями.
На исключительно важную роль бактериальных токсинов в развитии пищевых токсикоинфекций указывает и относительно короткий инкубационный период заболевания.
В зависимости от типов токсинов они могут вызывать гиперсекрецию жидкости в просвет кишечника, клинические проявления гастроэнтерита и системные проявления заболевания в виде синдрома интоксикации.
На исключительно важную роль бактериальных токсинов в развитии пищевых токсикоинфекций указывает и относительно короткий инкубационный период заболевания.
В зависимости от типов токсинов они могут вызывать гиперсекрецию жидкости в просвет кишечника, клинические проявления гастроэнтерита и системные проявления заболевания в виде синдрома интоксикации.
Слайд 18Инкубационный период. Составляет, как правило, несколько часов, однако в отдельных случаях
он может укорачиваться до 30 мин или, наоборот, удлиняться до 24 ч и более.
Слайд 19Для заболеваний характерно острое начало с тошноты, повторной рвоты, жидкого стула
энтеритного характера от нескольких до 10 раз в сутки и более.
Боли в животе и температурная реакция могут быть незначительными, однако в части случаев наблюдают сильные схваткообразные боли в животе,
кратковременное (до суток) повышение температуры тела до 38-390 С, озноб,
общая слабость, недомогание, головная боль.
Боли в животе и температурная реакция могут быть незначительными, однако в части случаев наблюдают сильные схваткообразные боли в животе,
кратковременное (до суток) повышение температуры тела до 38-390 С, озноб,
общая слабость, недомогание, головная боль.
Слайд 23 При осмотре больных отмечают бледность кожных покровов, иногда периферический цианоз,
похолодание конечностей,
болезненность при пальпации в эпигастральной и пупочной областях,
изменения частоты пульса и снижение артериального давления.
Степень выраженности клинических проявлений дегидратации и деминерализации зависит от объёма жидкости, теряемой больными при рвоте и диарее.
Течение заболевания короткое и в большинстве случаев составляет 1-3 дня.
болезненность при пальпации в эпигастральной и пупочной областях,
изменения частоты пульса и снижение артериального давления.
Степень выраженности клинических проявлений дегидратации и деминерализации зависит от объёма жидкости, теряемой больными при рвоте и диарее.
Течение заболевания короткое и в большинстве случаев составляет 1-3 дня.
Слайд 25Стафилококковой инфекции свойственны короткий инкубационный период и бурное развитие симптомов заболевания.
В клинической картине доминируют признаки гастрита: многократная рвота, резкие боли в эпигастральной области, напоминающие желудочные колики.
Характер стула может не меняться.
Температура тела в большинстве случаев остаётся нормальной или кратковременно повышается.
Выраженное снижение артериального давления, цианоз и судороги можно наблюдать уже в первые часы заболевания, но в целом течение болезни кратковременное и благоприятное
Слайд 26Диагностика -Пищевые токсикоинфекции
Наибольшее значение в диагностике ПТИ имеют клинико-эпидемиологические данные.
Среди них:
1) острое начало и доминирование в клинической картине симптомов гастрита или гастроэнтерита;
2) отсутствие гипертермии или ее кратковременный характер;
3) короткий инкубационный период и непродолжительность самого заболевания;
4) групповой характер заболеваемости и ее связь с употреблением одного и того же пищевого продукта;
5) эксплозивный (взрывной) характер заболеваемости.
1) острое начало и доминирование в клинической картине симптомов гастрита или гастроэнтерита;
2) отсутствие гипертермии или ее кратковременный характер;
3) короткий инкубационный период и непродолжительность самого заболевания;
4) групповой характер заболеваемости и ее связь с употреблением одного и того же пищевого продукта;
5) эксплозивный (взрывной) характер заболеваемости.
Слайд 27Лабораторная диагностика пищевых токсикоинфекций
Диагноз пищевой токсикоинфекции подтверждают следующими методами:
- бактериологический. Для исследования берут
рвотные массы, промывные воды желудка (первые порции), кал, остатки пищи, а при подозрении на сепсис — также кровь, мочу. Материал забирают до начала лечения противомикробными препаратами. Посевы делают на плотные дифференциальные среды — агар Эндо или Левина, Плоскирева, желточно-солевой агар.
- серологический. Положительная реакция аглютинации (РА) и другие иммунологические реакции с автоштамом вероятного возбудителя, рост титра антител в 4 раза и более в динамике заболевания в парных сыворотках крови, которые принимают при госпитализации больного и через 7-10 дней.
- серологический. Положительная реакция аглютинации (РА) и другие иммунологические реакции с автоштамом вероятного возбудителя, рост титра антител в 4 раза и более в динамике заболевания в парных сыворотках крови, которые принимают при госпитализации больного и через 7-10 дней.
Слайд 30Лечение.
Больные с пищевыми токсикоинфекциями должны направляться в инфекционные стационары.
Лечение можно
проводить и в домашних условиях под наблюдением врача кабинета инфекционных заболеваний.
Лечение начинают с промывания желудка. Промывание проводят желудочным зондом независимо от времени, прошедшего от начала заболевания. Применяют 2% раствор гидрокарбоната натрия или 0,1% раствор перманганата калия не менее 3 л.
При легком течении пищевых токсикоинфекций, когда тошнота или рвота прекратились, назначают внутрь глюкозоэлектролитный раствор, содержащий в 1 л кипяченой воды хлорида натрия — 3,5 г, гидрокарбоната натрия — 2,5 г, хлорида калия — 1,5 г и глюкозы — 20 г. Можно применять также официальные препараты «Регидрон» и «Глюкосолан» в пакетах.
Лечение начинают с промывания желудка. Промывание проводят желудочным зондом независимо от времени, прошедшего от начала заболевания. Применяют 2% раствор гидрокарбоната натрия или 0,1% раствор перманганата калия не менее 3 л.
При легком течении пищевых токсикоинфекций, когда тошнота или рвота прекратились, назначают внутрь глюкозоэлектролитный раствор, содержащий в 1 л кипяченой воды хлорида натрия — 3,5 г, гидрокарбоната натрия — 2,5 г, хлорида калия — 1,5 г и глюкозы — 20 г. Можно применять также официальные препараты «Регидрон» и «Глюкосолан» в пакетах.
Слайд 33При тяжелом течении, инфекционно-токсическом шоке, неукротимой рвоте и выраженном обезвоживании глюкозоэлектролитные
растворы вводят внутривенно. Применяют полиионные растворы «Трисоль», «Хлосоль», «Квартасоль». Если потери жидкости достигают 7% от массы тела, то растворы вводят струйно.
Слайд 34При тяжелой рвоте можно применять противорвотные средства, например дименгидринат по 50
мг внутримышечно каждые 4 ч
Антибиотики оказывают быстрый эффект, но применение их чревато опасным повреждением слизистой оболочки кишечника.
В связи с этим лучше применять сульфаниламиды (бисептол) по 2 таблетки 2 раза в день) или галогеносодержащие оксихинолины (интетрикс по 1 капсуле 3— раза в день) в течение 5дней.
Хорошим симптоматическим эффектом обладают адсорбенты, обволакивающие и противовоспалительные средства (танин, уголь медицинский, препараты висмута, пектины и др.). Медицинский уголь назначают в дозе от 1 до 4 таблеток до 3 раз в день, каждый раз после жидкого стула.
Антибиотики оказывают быстрый эффект, но применение их чревато опасным повреждением слизистой оболочки кишечника.
В связи с этим лучше применять сульфаниламиды (бисептол) по 2 таблетки 2 раза в день) или галогеносодержащие оксихинолины (интетрикс по 1 капсуле 3— раза в день) в течение 5дней.
Хорошим симптоматическим эффектом обладают адсорбенты, обволакивающие и противовоспалительные средства (танин, уголь медицинский, препараты висмута, пектины и др.). Медицинский уголь назначают в дозе от 1 до 4 таблеток до 3 раз в день, каждый раз после жидкого стула.
Слайд 35
Всем больным назначают щадящую диету (№ 4, затем № 46).
В
качестве противорвотного средства рекомендуется: в 50 мл теплой воды развести 10 г картофельного крахмала, размешать, добавить 10 г сахарного песка, 0,4 г лимонного сока (лимонной кислоты). Вскипятить 150 мл воды и в кипяток влить полученный раствор крахмала. После охлаждения добавить 2,0--3,0 г 5%-ного спиртового раствора йода. Принимать от 1 до 8 ч. л. 3 раза в день в течение 5 дней.
Прогноз заболевания обычно благоприятный. Смертельные исходы наблюдаются редко и обусловлены такими осложнениями, как дегидратационный шок, острая сердечная недостаточность, некротический энтерит, анаэробный сепсис.
Прогноз заболевания обычно благоприятный. Смертельные исходы наблюдаются редко и обусловлены такими осложнениями, как дегидратационный шок, острая сердечная недостаточность, некротический энтерит, анаэробный сепсис.
Слайд 36Фитотерапия
Фитотерапия направлена на восстановление всех функций кишечника. Применяют следующие растительные средства:
ольховые шишки, горец змеиный, кору дуба, конский щавель, землянику, лапчатку прямостоячую, плоды черемухи, тмин обыкновенный, ягоды и листья черники, ромашку, чагу.
Можно использовать следующие сборы:
1. Ягоды черники -- 20,0 г.
Листья мяты -- 20,0 г.
Корневище горца змеиного -- 20,0 г.
Цветки ромашки аптечной -- 30,0 г.
Настой принимают в теплом виде 3--4 раза в день по 1/2 стакана за 20--30 минут до еды.
2. Черемуха обыкновенная (плоды) -- 60,0 г.
Черника обыкновенная (плоды) -- 40,0 г.
Принимать по 1/4--1/2 стакана отвара 3--4 раза в день.
Можно использовать следующие сборы:
1. Ягоды черники -- 20,0 г.
Листья мяты -- 20,0 г.
Корневище горца змеиного -- 20,0 г.
Цветки ромашки аптечной -- 30,0 г.
Настой принимают в теплом виде 3--4 раза в день по 1/2 стакана за 20--30 минут до еды.
2. Черемуха обыкновенная (плоды) -- 60,0 г.
Черника обыкновенная (плоды) -- 40,0 г.
Принимать по 1/4--1/2 стакана отвара 3--4 раза в день.
Слайд 37Профилактика.
Залогом успешной борьбы с ПТИ являются широкое проведение государственных мероприятий:
создание современных, механизированных и автоматизированных предприятий пищевой промышленности, разработка и внедрение в практику новых методов консервирования и хранения скоропортящихся продуктов.
Большое значение имеют усиление требований к качеству пищевых продуктов, действенная и повсеместно существующая санитарная служба на предприятиях пищевой промышленности, общественного питания и торговли.
Важнейшей профилактической мерой при стафилококковой интоксикации является отстранение от работы лиц с гнойничковыми заболеваниями кожи, ангинами и др., соприкасающихся с продуктами питания (работники пищевых предприятий, столовых, продовольственных магазинов). Большая ответственность лежит на ветеринарной службе, осуществляющей надзор за здоровьем молочного скота.
Большое значение имеют усиление требований к качеству пищевых продуктов, действенная и повсеместно существующая санитарная служба на предприятиях пищевой промышленности, общественного питания и торговли.
Важнейшей профилактической мерой при стафилококковой интоксикации является отстранение от работы лиц с гнойничковыми заболеваниями кожи, ангинами и др., соприкасающихся с продуктами питания (работники пищевых предприятий, столовых, продовольственных магазинов). Большая ответственность лежит на ветеринарной службе, осуществляющей надзор за здоровьем молочного скота.
Слайд 38Медсестринский процесс
І Этап. Медсестринское обследование.
Жалобы пациента:
Тошнота, рвота;
Боль в животе;
Расстройство
стула;
Снижение аппетита;
Общая слабость;
Головная боль;
Озноб, повышение температуры.
Снижение аппетита;
Общая слабость;
Головная боль;
Озноб, повышение температуры.
Слайд 39Медсестринский процесс
І Этап. Медсестринское обследование.
Осмотр:
-Температура тела 38-39°С, тахикардия, гипотензия;
Кожа бледная, сухая;
Язык с бело-серым налетом;
Живот умеренно вздут, при пальпации болезненный, но мягкий;
Рвотные массы водянистые;
Фекалии калово-водянистые без слизи, крови, гноя.
Слайд 40ІІ етап. Медсестринская диагностика:
Тошнота, рвота.
Боль в животе.
Диарея.
Лихорадка.
Обезвоживание.
Слайд 41III этап - Планирование медсестринских вмешательств
1. Подготовка пациента и забор материала
для исследования.
2. Подготовка пациента и проведение мероприятий по неотложной медицинской помощи.
3. Решение проблем и потребностей пациента.
4. Выполнение врачебных назначений.
5. Решение сопутствующих проблем пациента.
6. Обучение пациента и его окружающих санитарно-гигиеническим навыкам, правилам само- и взаимоухода.
2. Подготовка пациента и проведение мероприятий по неотложной медицинской помощи.
3. Решение проблем и потребностей пациента.
4. Выполнение врачебных назначений.
5. Решение сопутствующих проблем пациента.
6. Обучение пациента и его окружающих санитарно-гигиеническим навыкам, правилам само- и взаимоухода.
Слайд 42 ІV этап. Реализация плана медсестринских вмешательств
Немедленно промывание желудка;
Очистительная или
сифонная клизма;
Забор рвотных масс и промывных вод, испражнений на бак.исследование;
Забор крови на бак. и серологическое исследование;
Контроль за частотой стула, колличеством, цветом, консистенцией, наличием патологических примесей;
Уход при лихорадке ;
Уход при рвоте;
Контроль и помощь в соблюдении диеты;
Контроль за соблюдением правил личной гигиены пациентом;
Постоянный контроль за самочувствием и объективным состоянием пациента, измерения температуры тела, пульса, АД ;
Контроль за текущей дезинфекцией.
Забор рвотных масс и промывных вод, испражнений на бак.исследование;
Забор крови на бак. и серологическое исследование;
Контроль за частотой стула, колличеством, цветом, консистенцией, наличием патологических примесей;
Уход при лихорадке ;
Уход при рвоте;
Контроль и помощь в соблюдении диеты;
Контроль за соблюдением правил личной гигиены пациентом;
Постоянный контроль за самочувствием и объективным состоянием пациента, измерения температуры тела, пульса, АД ;
Контроль за текущей дезинфекцией.
Слайд 43Выполнение врачебных назначений :
Перорально: сорбенты, дезинтоксикационные средства (оралит, регидрон), ферментные препараты
(фестал, панзинорм);
Парэнтеральная регидратация (при тяжелых формах) – в/в капельно изотонический р-р, “Квартасоль”, “Трисоль” и др.
При угрозе развития сепсиса и тяжелых состояниях – антибактериальные средства.
Парэнтеральная регидратация (при тяжелых формах) – в/в капельно изотонический р-р, “Квартасоль”, “Трисоль” и др.
При угрозе развития сепсиса и тяжелых состояниях – антибактериальные средства.
Слайд 44 V этап. Оценка результатов медсестринских вмешательств и их коррекция :
Улучшение
общего состояния, нормализация пульса, АД, аппетита, опорожнений, отсутствие рвоты;
Коррекция медсестринских вмешательств (при необходимости повторное промывание желудка, кишечника).
Коррекция медсестринских вмешательств (при необходимости повторное промывание желудка, кишечника).
Слайд 45 Каждый человек обязан еще и
сам заботиться о своем здоровье. А для этого надо:
тщательно мыть руки с мылом после посещения туалета, перед приготовлением пищи и перед едой;
кипятить любое молоко, кроме того, которое продается в магазинах в бутылках и пакетах;
из творога в жаркое время года лучше делать запеканки, сырники, вареники;
иметь в хозяйстве несколько разделочных досок и одну из них выделить только для сырого мяса и сырой птицы. Закончив разделку этих продуктов, обязательно вымыть с мылом и обдать кипятком доску и нож, тщательно вымыть руки;
продукты и блюда, которые перед едой не проваривают и не прожаривают — салат, заливное, студень, паштет, крем, желе, сырковую массу — попробовать на вкус. Если продукт испорчен ни в коем случаи не употреблять его.
тщательно мыть руки с мылом после посещения туалета, перед приготовлением пищи и перед едой;
кипятить любое молоко, кроме того, которое продается в магазинах в бутылках и пакетах;
из творога в жаркое время года лучше делать запеканки, сырники, вареники;
иметь в хозяйстве несколько разделочных досок и одну из них выделить только для сырого мяса и сырой птицы. Закончив разделку этих продуктов, обязательно вымыть с мылом и обдать кипятком доску и нож, тщательно вымыть руки;
продукты и блюда, которые перед едой не проваривают и не прожаривают — салат, заливное, студень, паштет, крем, желе, сырковую массу — попробовать на вкус. Если продукт испорчен ни в коем случаи не употреблять его.